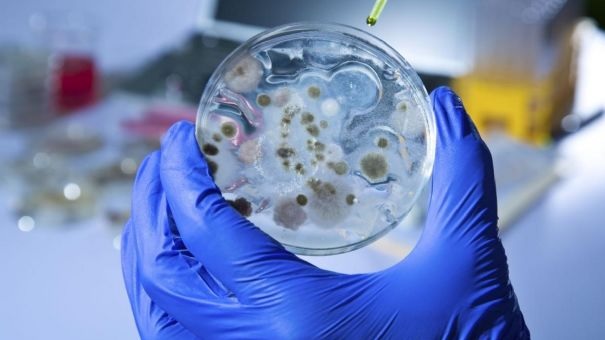
Ántrax

La OMS advierte del peligro de un nuevo brote de Ántrax en África por la rapidez con la que se expande y el número de muertos
Un brote de ántrax declarado en Zambia el pasado 1 de noviembre comenzó a preocupar a la Organización Mundial de la Salud (OMS) ante el aumento en el número de muertos.
La OMS advirtió que el brote se ha registrado en cinco países de África, y que el que más le preocupa es Zambia, en donde se expandió a nueve de sus diez provincias.
Informó que hasta el pasado 20 de noviembre, Zambia reportó 684 casos sospechosos, 25 confirmados y cuatro muertes por esta enfermedad.
[caption id="attachment_186073" align="alignnone" width="1200"]

La muerte de elefantes en África sería por el brote de Ántrax.[/caption]
Autoridades registraron más casos en Kenia, Malaui, Uganda y Zimbabue.
Y aunque la autoridad sanitaria aclaró que por el momento solo se han notificado “casos esporádicos”, lanzó una advertencia al mundo debido a su rápido avance, pues se han registrado más muertes que en otros años.
El ántrax es una enfermedad endémica en varios países de
África, donde surgen brotes estacionales cada año, pero esta vez se han reportado más muertes debido a que los enfermos llegan muy tarde a los hospitales.
[caption id="attachment_186074" align="alignnone" width="605"]
El brote de ántrax lo habrían causado el contacto con animales muertos contagiados o comer su carne. Foto: Especial[/caption]
La OMS explicó que el
brote de ántrax se debe a la exposición de la población que manipula cadáveres de animales que habían muerto repentinamente y al comer carne de animales infectados.
Señala que el peligro está en el constante desplazamiento de animales y personas, y que el
brote de ántrax podría alcanzar a países como Mozambique, Angola, Botsuana, Malaui, Namibia, Tanzania, Uganda y Zimbabue.
*GG